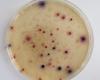

A mikroorganizmusok tenyésztése megfelelő tápközegekben történhet, melyeknek tartalmazniuk kell az esszenciális tápanyagokat megfelelő mennyiségben, minőségben és a sejt számára metabolizálható (felvehető, hasznosítható) formában. Ezek a tápanyagok a következők:
- biogén elemek: C, N, O, H
- a plazma felépítéséhez szükséges ásványi elemek: P, S, Cl, Fe, K, Na, Ca, Mg
- elemnyomként kis mennyiségben: Cu, Zn, Co, Mo stb...
Megkülönböztetünk természetes és szintetikus tápközegeket.
Természetes tápközegek: növényi vagy állati szövetek kivonatai csapvízzel elkeverve. Hátrányuk, hogy összetételük változó, nem pontosan ismert. Pl.: húslé, malátalé, gyümölcscefrék, steril tej.
Szintetikus tápközegek: tiszta anyagok desztillált vagy ioncserélt vízben készített oldatai. Ehhez a bioszanyagokat vitamin, vagy természetes táptalaj (élesztőkivonat) formájában adagolják. Szénforrásként tartalmazhatnak egyszerű, vagy összetett szénhidrátokat, alkoholokat, szerves savak sóit. Nitrogénforrásként szerves nitrogénvegyületek (fehérjék, peptonok, aminosavak) vagy szervetlen nitrogénvegyületeket (ammóniumsók, nitrátok) szerepelhetnek. Az ásványi anyagokat só formájában adagolják a tápközegekhez.
A tápközegek lehetnek folyékony vagy szilárd halmazállapotúak. A szilárd táptalajokat vagy tápoldatokból állítjuk elő gélképző szilárdító adalékokkal vagy szilárd halmazállapotú alapanyagokat használunk megfelelő nedvességtartalomra beállítva
Felhasználhatóságuk szerint megkülönböztethetünk több mikroorganizmus faj szaporításához használható általános tápközegeket és néhány, vagy csak egyetlen mikroorganizmus faj szapotítására alkalmas szelektív tápközegeket.
BME Vegyészmérnöki Kar Tanszéki Munkaközösség (1993) Ipari mikrobiológiai gyakorlatok, (Szerkesztő: Puskás, A.) Műegyetemi Kiadó, Budapest